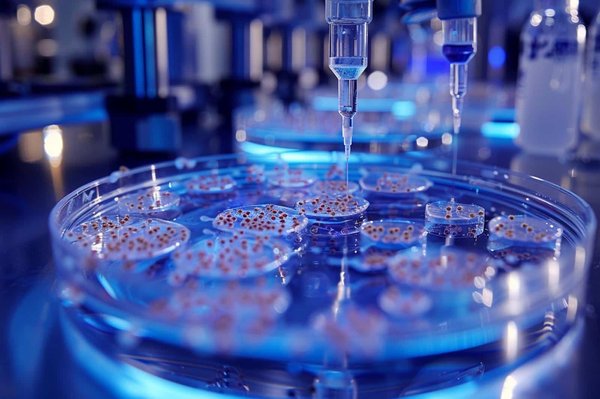
How Are Synthetic Phages Being Engineered to Combat Antibiotic-Resistant Bacteria?

Can Smart Infrastructure Reduce Urban Congestion and Improve Commuter Experiences?
With cities becoming increasingly crammed and public transportation overburdened, urban congestion is an all-too-common problem. But thanks to a wave ...

With cities becoming increasingly crammed and public transportation overburdened, urban congestion is an all-too-common problem. But thanks to a wave ...

In the sphere of education, there's an emergent wave of transformation sweeping across, brought about by advancements in technology, especially Artifi...

Unlock the excitement of unboxing with the hottest mystery boxes on the market! These surprise-filled packages cater to all ages and interests, making...
If you have been keeping tabs on the latest news in the medical world, you have probably heard about antibiotic-resistant bacteria. As scary as it sou...

Mario Mystery Boxes capture the essence of surprise and strategy in the Super Mario universe. These iconic items not only add excitement to gameplay b...

Cancer remains one of the most formidable health challenges of our time. Traditional diagnostic methods like tissue biopsies are invasive and can at t...